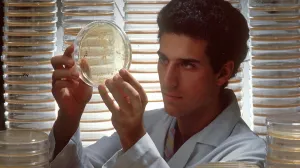
biolog, naučnik, doktor, istraživač, hemičar/National Cancer Institute

Bill Gates prvi put od 1991. nije među 10 najbogatijih Amerikanaca

Bill Gates dugo je bio poznat kao najbogatija osoba u Americi, a počevši od 1991. godine, gotovo tri decenije zauzimao je prvo ili drugo mjesto na Forbesovoj listi 400 najbogatijih ljudi u zemlji.
Godine 2021. pao je ispod drugog mjesta, a sada, prvi put nakon 34 godine, Gates nije ni među prvih deset. Na ovogodišnjoj Forbesovoj listi 400 zauzima 14. mjesto, odmah iza suosnivača Bloomberg LP-a Mikea Bloomberga i jedno mjesto ispred najbogatije žene u zemlji i svijetu, nasljednice Walmarta Alice Walton.
Naravno, Gates i dalje raspolaže ogromnim bogatstvom – Forbes procjenjuje da vrijedi 107 milijardi dolara, isto kao i prošle godine. Dok drugi milijarderi na listi postaju sve bogatiji, Gates ima drugačije planove.
U maju je najavio da planira pokloniti 99% preostalog bogatstva svojoj dobrotvornoj Zakladi Gates u naredna dva desetljeća. Zaklada će zatvoriti svoja vrata 2045. godine, kada će Gates napuniti 90 godina.
Kako bi se "rastao" od 99 posto svog bogatstva, Gates planira donirati "milijarde godišnje" zakladi.
- Neće biti jednaki iznosi svake godine jer će donekle zavisiti od toga šta se dešava na tržištima, rekao je za Forbes u maju i dodao:
- Moja oporuka je vrlo jasna da, kada umrem, sav taj novac ide u zakladu i oni će morati shvatiti šta će s imovinom.
Forbes procjenjuje da je Gates od prošlogodišnje objave liste Forbes 400 donirao sedam milijardi dolara Zakladi Gates.
Gatesov pad na ljestvici američkih milijardera započeo je godine kada su se on i Melinda French Gates, njegova supruga s kojom je bio u braku 27 godina, razveli. Pao je na 4. mjesto na Forbes 400 listi za 2021. godinu, s procijenjenom vrijednošću od 134 milijarde dolara.
Prije godinu dana pao je na 9. mjesto, s vrijednošću od 107 milijardi dolara. Pad neto vrijednosti uslijedio je nakon što je French Gates dala ostavku na mjesto supredsjednice Zaklade Gates i najavila da će u sklopu odlaska dobiti 12,5 milijardi dolara za vlastitu filantropiju. Čini se da su ta sredstva prenesena iz bogatstva Billa Gatesa.
Forbes sada procjenjuje da je, osim novca za filantropiju, French Gates dobila imovinu vrijednu 29 milijardi dolara kao dio brakorazvodne nagodbe.
Suosnivač Microsofta, koji će u oktobru napuniti 70 godina, postavio je velike ciljeve za Zakladu Gates u nadolazećim desetljećima. Jedan od ciljeva je da nijedna majka, beba ili dijete ne umre od uzroka koji se mogu spriječiti.
Zaklada će nastaviti i s naporima za iskorjenjivanje dječije paralize i smanjenje utjecaja malarije, što je dio šire misije zaklade da se ograniči širenje zaraznih bolesti. U međuvremenu, Gatesova neto vrijednost će vjerovatno nastaviti padati, gurajući ga sve niže na listi Forbes 400, prenosi Index.hr.